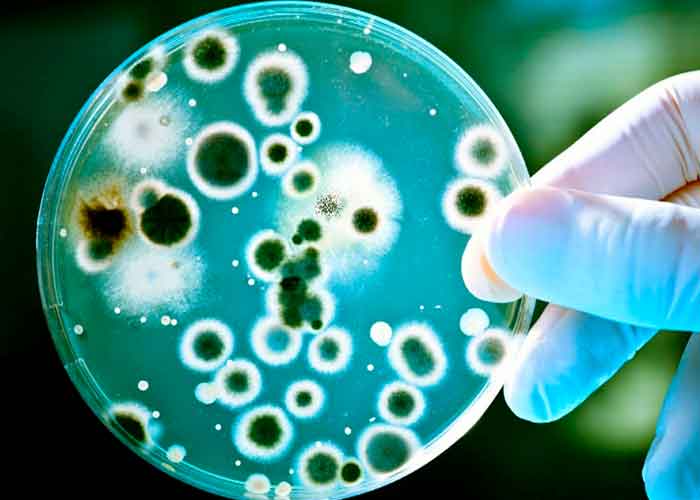

El estado del microbioma intestinal de una persona puede desempeñar un papel importante en la lucha del organismo contra la infección por coronavirus y la prevención de los síntomas graves de covid-19, han concluido dos nuevos estudios de científicos de chinos y surcoreanos.
Esta variedad única de bacterias del intestino desempeña varias funciones, una de las cuales es la modulación de la respuesta inmunitaria del organismo. Los investigadores de la Universidad China de Hong Kong hallaron que la composición de microbioma de las personas con covid-19 estaba "significativamente alterada".
Lee también: Activan un robot que hace pruebas de covid-19 en China
Cien pacientes examinados
El equipo examinó la sangre, las heces y los historiales médicos de cien pacientes ingresados con coronavirus en hospitales entre febrero y mayo del año pasado, 27 de los cuales siguieron proporcionando muestras un mes después de recuperarse de la infección. Además, fueron analizadas las muestras de 78 personas sin covid-19 que estaban participando en un estudio sobre el microbioma antes de la pandemia.

Los investigadores llegaron a la conclusión de que el microbioma intestinal puede estar relacionado con la "magnitud de la gravedad de covid-19, posiblemente a través de la modulación de las respuestas inmunitarias del huésped", después de que encontraran que los pacientes tenían niveles reducidos de varias bacterias intestinales que se sabe que modifican la respuesta inmune del organismo (como 'Faecalibacterium prausnitzii' y 'Bifidobacterium bifidum'). En cambio, otros tipos de bacterias estaban presentes en niveles elevados.
La alteración en la composición bacteriana del intestino perduró al menos 30 días después de que el coronavirus fuera eliminado del organismo. Basándose en ello, los autores estimaron "que el microbioma intestinal disbiótico podría contribuir a problemas de salud relacionados con el sistema inmunológico posteriores al covid-19".
Por otra parte, las muestras de sangre revelaron que el desequilibrio microbiano en el intestino también estaba asociado con niveles más altos de citocinas, moléculas de la respuesta inmune que durante el covid-19 pueden empezar a atacar las células y tejidos sanos en un fenómeno conocido como 'tormenta de citocinas'. Este estado puede conducir al síndrome de dificultad respiratoria aguda (SDRA), una condición potencialmente fatal.

Otro estudio separado, publicado en la revista médica en línea mBio, encontró que una mala salud intestinal afecta negativamente el pronóstico del covid-19 y aumenta las probabilidades de desarrollar una forma más severa de la enfermedad, ya que la falta de microbios saludables facilita que el coronavirus infecte las células del tracto digestivo y órganos internos.
Los autores precisan que su estudio es de tipo observacional por lo que no puede establecer la causa y, además, el microbioma varía ampliamente entre poblaciones, por lo que los cambios observados en esta investigación "pueden no ser aplicables a otros pacientes con covid-19 en otros lugares".